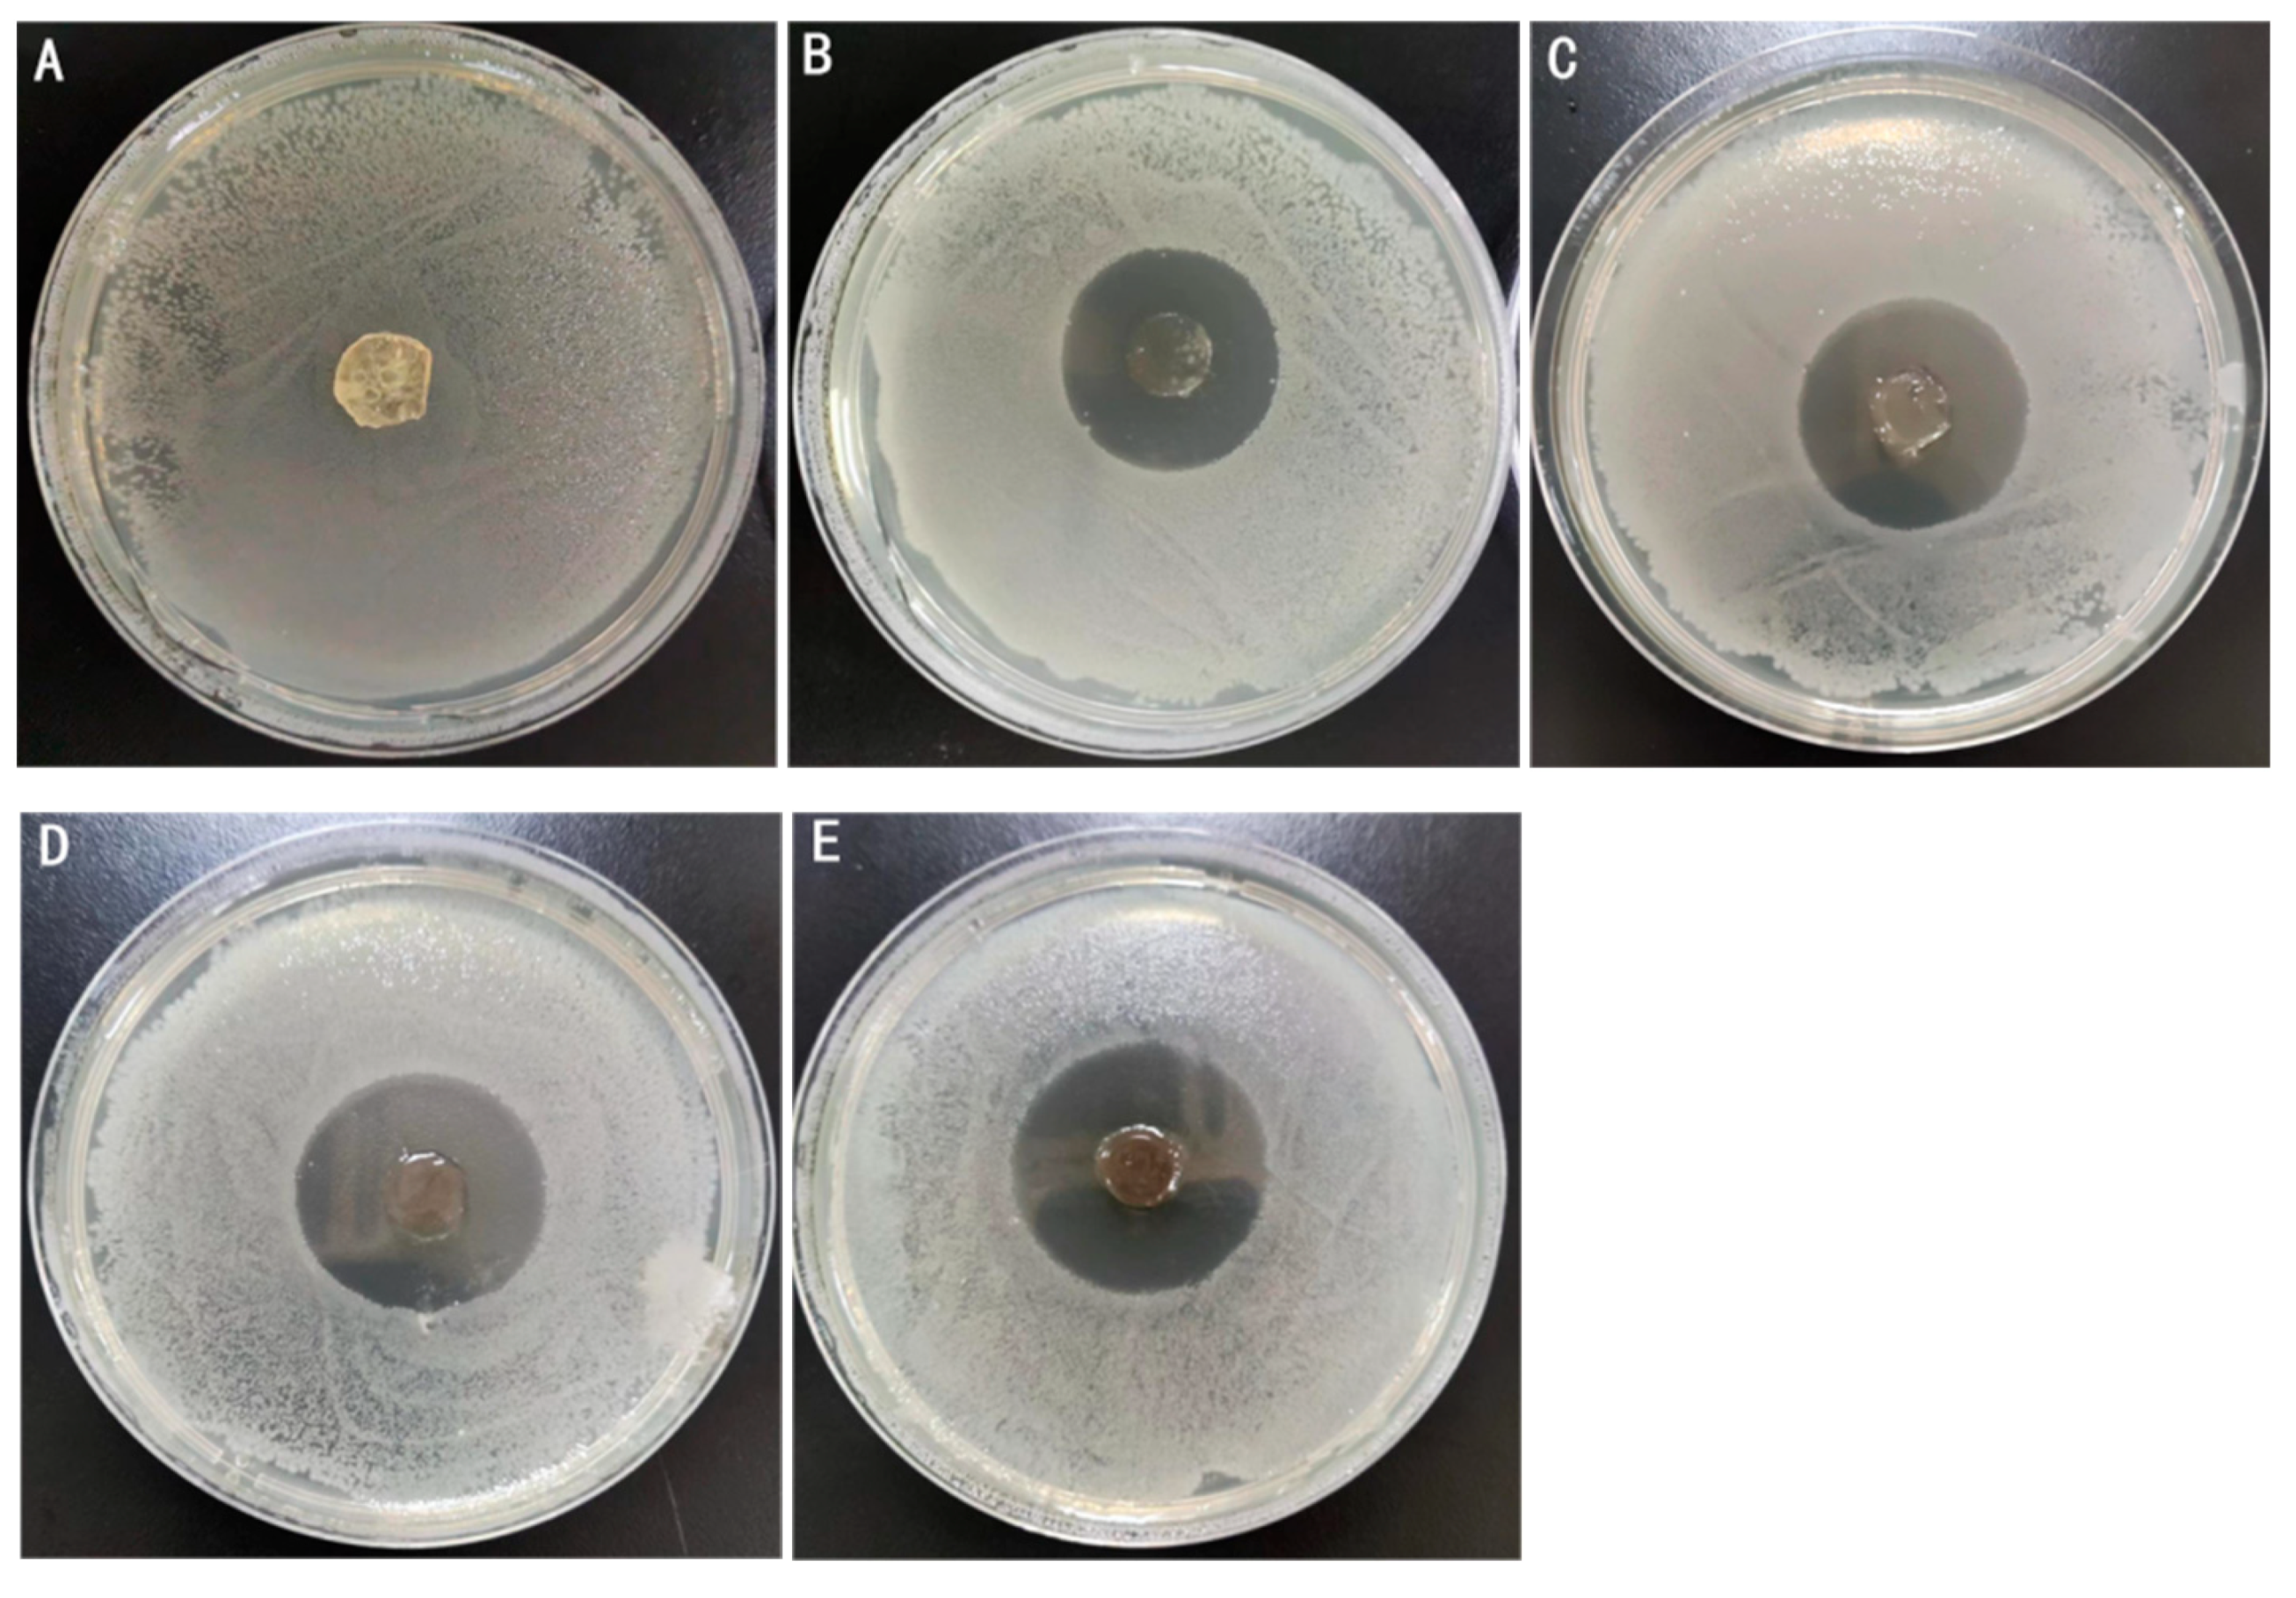
Gels 11 00407 g007
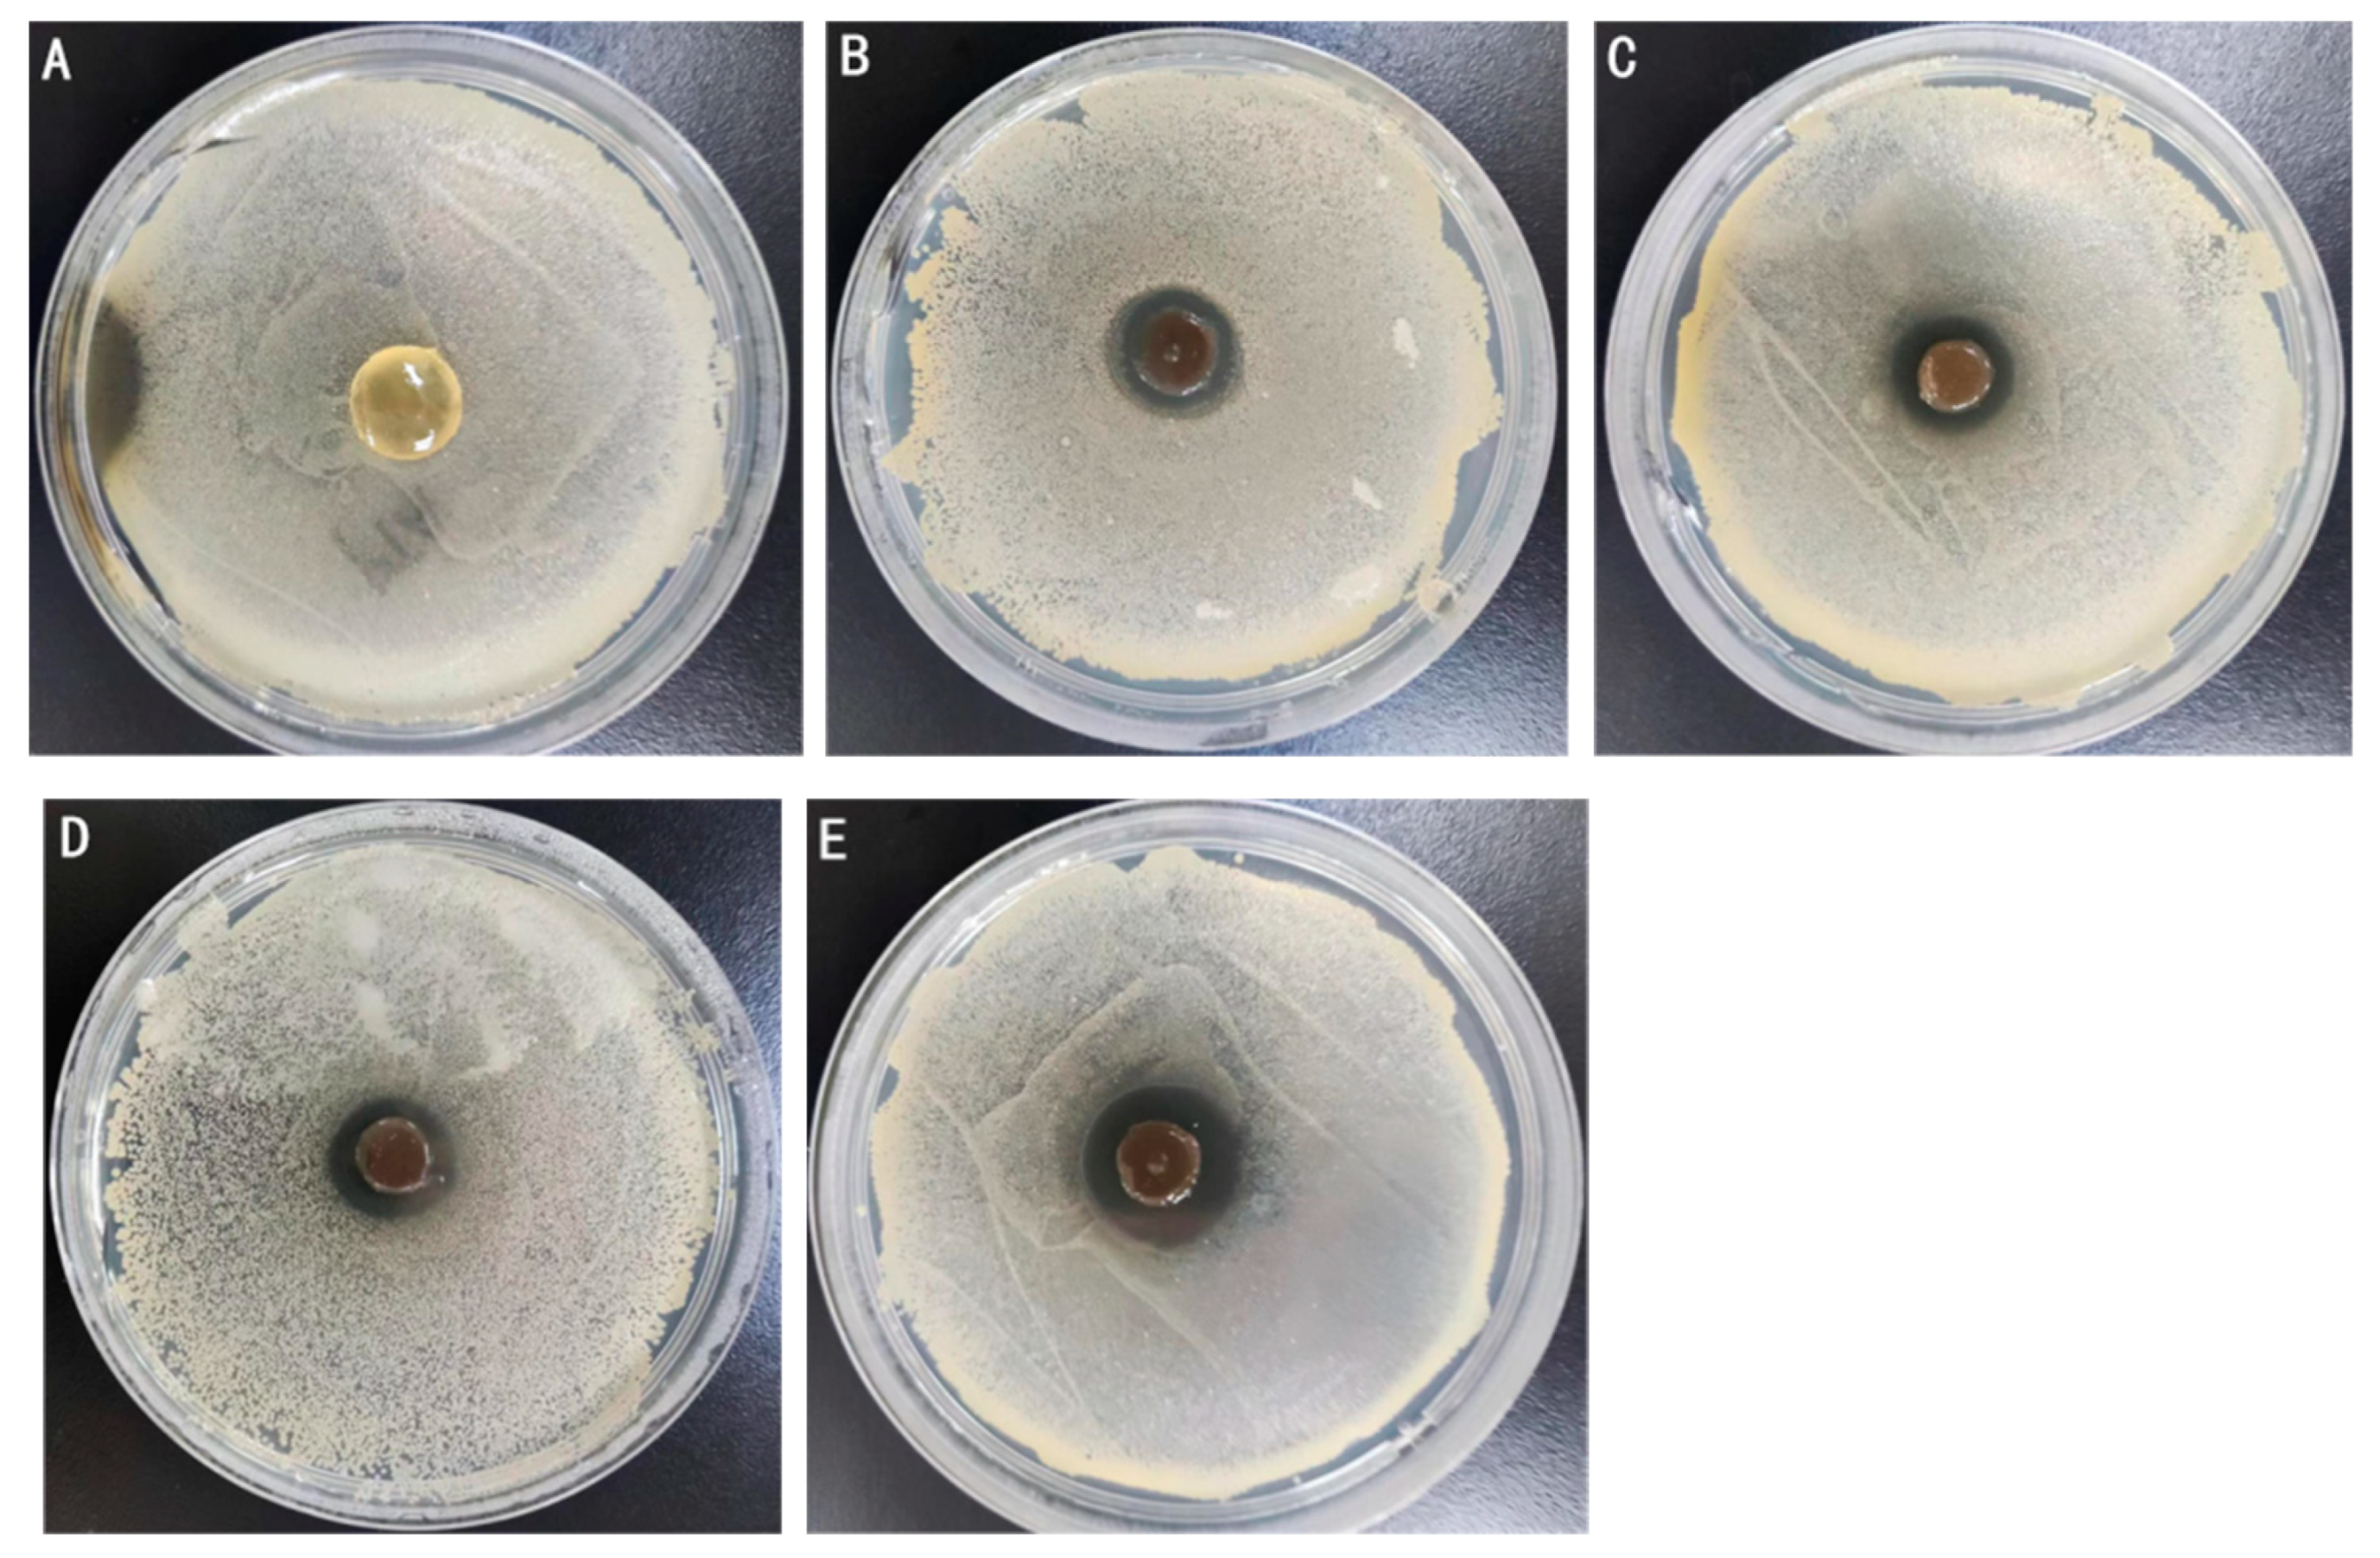
Gels 11 00407 g008

Performance Characterization and Antibacterial Activity of a Composite Hydrogel Composed of Oxidized κ-Carrageenan, Acrylamide, and Silver-Based Metal–Organic Frameworks
Abstract
1. Introduction
2. Results and Discussion
2.1. Characterization of Ag-MOFs
2.2. Physicochemical Properties of Ag-MOFs/OKC/PAM Hydrogel
2.2.1. Moisture Content and Water Solubility
2.2.2. Swelling Ratio
2.2.3. Mechanical Property
2.3. Scanning Electron Microscopy
2.4. Antimicrobial Activity
2.5. Cytotoxicity
3. Conclusions
4. Materials and Methods
4.1. Materials
4.2. Methods
4.2.1. Preparation of Oxidized κ-Carrageenan
4.2.2. Preparation and Characterization of Ag-MOFs
4.2.3. Preparation of Ag-MOFs/OKC/PAM Hydrogels
4.2.4. Physicochemical Properties Analysis of Ag-MOFs/OKC/PAM Hydrogels
4.2.5. Scanning Electron Microscopy Analysis of Ag-MOFs/OKC/PAM Hydrogels
4.2.6. Antimicrobial Activity of Ag-MOFs/OKC/PAM Hydrogels
4.2.7. Cytotoxicity Test of Ag-MOFs/OKC/PAM Hydrogels
4.2.8. Data Analysis
Author Contributions
Funding
Institutional Review Board Statement
Informed Consent Statement
Data Availability Statement
Conflicts of Interest
References
- Qureshi, M.A.U.R.; Arshad, N.; Rasool, A.; Islam, A.; Rizwan, M.; Haseeb, M.; Rasheed, T.; Bilal, M. Chitosan and Carrageenan-Based Biocompatible Hydrogel Platforms for Cosmeceutical, Drug Delivery, and Biomedical Applications. Starch-Starke 2024, 76, 2200052. [Google Scholar] [CrossRef]
- Dahal, P.; Janaswamy, S. Hydrocolloid-based nutraceutical delivery systems: Potential of κ-carrageenan hydrogel beads for sustained release of curcumin. Food Res. Int. 2024, 183, 114223. [Google Scholar] [CrossRef] [PubMed]
- Luo, Z.; Che, J.; Sun, L.; Yang, L.; Zu, Y.; Wang, H.; Zhao, Y. Microfluidic electrospray photo-crosslinkable κ-Carrageenan microparticles for wound healing. Eng. Regen. 2021, 2, 257–262. [Google Scholar] [CrossRef]
- Liu, Y.; Zhang, X.; Li, C.; Qin, Y.; Xiao, L.; Liu, J. Comparison of the structural, physical and functional properties of κ-carrageenan films incorporated with pomegranate flesh and peel extracts. Int. J. Biol. Macromol. 2020, 147, 1076–1088. [Google Scholar] [CrossRef]
- Zhao, J.; Sun, C.; Li, H.; Dong, X.; Zhang, X. Studies on the physicochemical properties, gelling behavior and drug release performance of agar/κ-carrageenan mixed hydrogels. Int. J. Biol. Macromol. 2020, 154, 878–887. [Google Scholar] [CrossRef]
- Ulagesan, S.; Krishnan, S.; Nam, T.-J.; Choi, Y.-H. The Influence of κ-Carrageenan-R-Phycoerythrin Hydrogel on In Vitro Wound Healing and Biological Function. Int. J. Mol. Sci. 2023, 24, 12358. [Google Scholar] [CrossRef]
- Gubaidullin, A.T.; Makarova, A.O.; Derkach, S.R.; Voron’ko, N.G.; Kadyirov, A.I.; Ziganshina, S.A.; Salnikov, V.V.; Zueva, O.S.; Zuev, Y.F. Modulation of Molecular Structure and Mechanical Properties of κ-Carrageenan-Gelatin Hydrogel with Multi-Walled Carbon Nanotubes. Polymers 2022, 14, 2346. [Google Scholar] [CrossRef]
- Pahnavar, Z.; Ghaemy, M.; Naji, L.; Hasantabar, V. Self-extinguished and flexible cation exchange membranes based on modified K-Carrageenan/PVA double network hydrogels for electrochemical applications. Int. J. Biol. Macromol. 2023, 231, 123253. [Google Scholar] [CrossRef] [PubMed]
- Zhu, L.; Xu, J.; Song, J.; Qin, M.; Gu, S.; Sun, W.; You, Z. Transparent, stretchable and anti-freezing hybrid double-network organohydrogels. Sci. China Mater. 2022, 65, 2207–2216. [Google Scholar] [CrossRef]
- Zhang, J.; Chen, L.; Shen, B.; Chen, L.; Feng, J. Ultra-high strength poly(N-(2-hydroxyethyl)acrylamide)/chitosan hydrogel with “repelling and killing” bacteria property. Carbohydr. Polym. 2019, 225, 115160. [Google Scholar] [CrossRef]
- Li, Z.; Li, X.; Yang, S.; Pan, C.; Li, C.; Hu, X.; Zhao, Y.; Deng, J.; Qi, B. Preparation and haracterization of oxidized κ-carrageenan/polyacrylamide hydrogel. Food Ferment. Ind. 2024, 50, 153–160. (In Chinese) [Google Scholar]
- Lu, X.; Ye, J.; Zhang, D.; Xie, R.; Bogale, R.F.; Sun, Y.; Zhao, L.; Zhao, Q.; Ning, G. Silver carboxylate metal-organic frameworks with highly antibacterial activity and biocompatibility. J. Inorg. Biochem. 2014, 138, 114–121. [Google Scholar] [CrossRef] [PubMed]
- Gniadecka, M.; Nielsen, O.F.; Wulf, H.C. Water content and structure in malignant and benign skin tumours. J. Mol. Struct. 2003, 661, 405–410. [Google Scholar] [CrossRef]
- Alavijeh, R.K.; Beheshti, S.; Akhbari, K.; Morsali, A. Investigation of reasons for metal-organic framework’s antibacterial activities. Polyhedron 2018, 156, 257–278. [Google Scholar] [CrossRef]
- Liu, J.; Wu, D.; Zhu, N.; Wu, Y.; Li, G. Antibacterial mechanisms and applications of metal-organic frameworks and their derived nanomaterials. Trends Food Sci. Technol. 2021, 109, 413–434. [Google Scholar] [CrossRef]
- Boonkaew, B.; Kempf, M.; Kimble, R.; Cuttle, L. Cytotoxicity testing of silver-containing burn treatments using primary and immortal skin cells. Burns 2014, 40, 1562–1569. [Google Scholar] [CrossRef]
- Zhang, W.; Ye, G.; Liao, D.; Chen, X.; Lu, C.; Nezamzadeh-Ejhieh, A.; Khan, M.S.; Liu, J.; Pan, Y.; Dai, Z. Recent Advances of Silver-Based Coordination Polymers on Antibacterial Applications. Molecules 2022, 27, 7166. [Google Scholar] [CrossRef] [PubMed]
- Jaros, S.W.; Król, J.; Bażanów, B.; Poradowski, D.; Chrószcz, A.; Nesterov, D.S.; Kirillov, A.M.; Smoleński, P. Antiviral, Antibacterial, Antifungal, and Cytotoxic Silver(I) BioMOF Assembled from 1,3,5-Triaza-7-Phoshaadamantane and Pyromellitic Acid. Molecules 2020, 25, 2119. [Google Scholar] [CrossRef]
- Cosenza, V.A.; Navarro, D.A.; Pujol, C.A.; Damonte, E.B.; Stortz, C.A. Partial and total C-6 oxidation of gelling carrageenans. Modulation of the antiviral activity with the anionic character. Carbohydr. Polym. 2015, 128, 199–206. [Google Scholar] [CrossRef]
- Jaros, S.W.; da Silva, F.C.G.M.; Król, J.; Oliveira, M.C.; Smoleński, P.; Pombeiro, A.J.L.; Alexander, M. Kirillov Bioactive Silver-Organic Networks Assembled from 1,3,5-Triaza-7-phosphaadamantane and Flexible Cyclohexanecarboxylate Blocks. Inorg. Chem. 2016, 55, 1486–1496. [Google Scholar] [CrossRef]
- Deng, Y.; Huang, M.; Sun, D.; Hou, Y.; Li, Y.; Dong, T.; Wang, X.; Zhang, L.; Yang, W. Dual Physically Cross-Linked κ-Carrageenan-Based Double Network Hydrogels with Superior Self-Healing Performance for Biomedical Application. Acs Appl. Mater. Interfaces 2018, 10, 37544–37554. [Google Scholar] [CrossRef] [PubMed]
- Zhang, Q.; Ren, T.; Gan, J.; Sun, L.; Guan, C.; Zhang, Q.; Pan, S.; Chen, H. Synthesis and Rheological Characterization of a Novel Salecan Hydrogel. Pharmaceutics 2022, 14, 1492. [Google Scholar] [CrossRef] [PubMed]
- Zhai, X.; Zou, X.; Shi, J.; Huang, X.; Sun, Z.; Li, Z.; Sun, Y.; Li, Y.; Wang, X.; Holmes, M.; et al. Amine-responsive bilayer films with improved illumination stability and electrochemical writing property for visual monitoring of meat spoilage. Sens. Actuators 2020, 302, 127130. [Google Scholar] [CrossRef]
- GB/T 20944.1-2007; Textiles—Evaluation for Antibacterial Activity—Part 1: Agar Diffusion Plate Method. General Administration of Quality Supervision, Inspection and Quarantine of the People’s Republic of China, China National Standards Administration: Beijing, China, 2007.

| Samples | Ag-MOFs/mg | OKC/g | AM/g | BIS/μL | TEMED/μL | APS/μL | KCl/mg | H2O/mL |
|---|---|---|---|---|---|---|---|---|
| A | 0 | 2.25 | 3 | 900 | 20 | 320 | 60 | 25 |
| B | 12 | 2.25 | 3 | 900 | 20 | 320 | 60 | 25 |
| C | 24 | 2.25 | 3 | 900 | 20 | 320 | 60 | 25 |
| D | 36 | 2.25 | 3 | 900 | 20 | 320 | 60 | 25 |
| E | 60 | 2.25 | 3 | 900 | 20 | 320 | 60 | 25 |
Disclaimer/Publisher’s Note: The statements, opinions and data contained in all publications are solely those of the individual author(s) and contributor(s) and not of MDPI and/or the editor(s). MDPI and/or the editor(s) disclaim responsibility for any injury to people or property resulting from any ideas, methods, instructions or products referred to in the content. |
© 2025 by the authors. Licensee MDPI, Basel, Switzerland. This article is an open access article distributed under the terms and conditions of the Creative Commons Attribution (CC BY) license (https://creativecommons.org/licenses/by/4.0/).
Share and Cite
Qi, B.; Li, Z.; Pan, C.; Zhao, Y.; Long, X.; Li, C.; Wang, Y.; Hu, X.; Wang, D.; Yang, S. Performance Characterization and Antibacterial Activity of a Composite Hydrogel Composed of Oxidized κ-Carrageenan, Acrylamide, and Silver-Based Metal–Organic Frameworks. Gels 2025, 11, 407. https://doi.org/10.3390/gels11060407
Qi B, Li Z, Pan C, Zhao Y, Long X, Li C, Wang Y, Hu X, Wang D, Yang S. Performance Characterization and Antibacterial Activity of a Composite Hydrogel Composed of Oxidized κ-Carrageenan, Acrylamide, and Silver-Based Metal–Organic Frameworks. Gels. 2025; 11(6):407. https://doi.org/10.3390/gels11060407
Chicago/Turabian StyleQi, Bo, Zhaoyu Li, Chuang Pan, Yongqiang Zhao, Xiaoshan Long, Chunsheng Li, Yueqi Wang, Xiao Hu, Di Wang, and Shaoling Yang. 2025. "Performance Characterization and Antibacterial Activity of a Composite Hydrogel Composed of Oxidized κ-Carrageenan, Acrylamide, and Silver-Based Metal–Organic Frameworks" Gels 11, no. 6: 407. https://doi.org/10.3390/gels11060407
APA StyleQi, B., Li, Z., Pan, C., Zhao, Y., Long, X., Li, C., Wang, Y., Hu, X., Wang, D., & Yang, S. (2025). Performance Characterization and Antibacterial Activity of a Composite Hydrogel Composed of Oxidized κ-Carrageenan, Acrylamide, and Silver-Based Metal–Organic Frameworks. Gels, 11(6), 407. https://doi.org/10.3390/gels11060407

